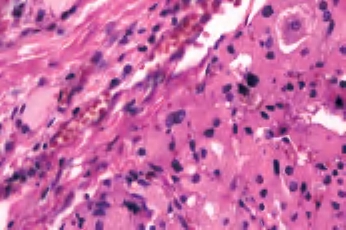
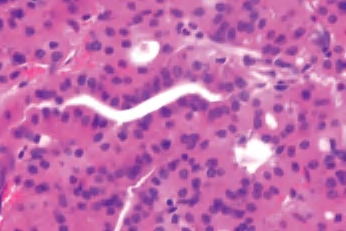

甲状腺腺瘤是常见的甲状腺肿瘤。滤泡性腺瘤的定义是显示滤泡细胞分化证据的具有包膜的良性肿瘤。大多数患者是甲状腺功能正常的成年人。
临床上首先表现为甲状腺肿块。扫描发现肿块通常为“冷”结节,有时为“凉”结节或“温”结节。很少伴有甲状腺功能亢进。
1.肉眼观察 通常是单发,圆形或椭圆形,有薄的包膜,包膜完整,切面呈灰白色、褐色或棕褐色。直径常为1~3cm,也可很大。
2.组织学诊断标准 ①有完整的包膜;②腺瘤与周围甲状腺的实质不同;③腺瘤内滤泡及滤泡上皮细胞大小较一致;④压迫周围甲状腺组织。
3.镜下 肿瘤细胞立方形、柱状或多角形,含一致深染的核。核分裂像罕见。继发病变包括间质水肿、纤维化、透明变性、出血、钙化,软骨化生、囊性变和梗死等(图3-31)。

图3-31 甲状腺滤泡性腺瘤
4.免疫组化 呈CK、TG和TTF-1免疫阳性;而CK19、CT及神经内分泌标记阴性。
5.鉴别诊断
(1)腺瘤样结节:一般多发性,缺乏完整的纤维包膜,但这种区别有时是相当武断的。
(2)滤泡性腺癌:具有较厚的纤维包膜,有明确的包膜与血管侵犯。
(3)甲状旁腺腺瘤:透明细胞的存在可以提供重要线索,进一步证实可采用甲状旁腺激素和嗜铬素阳性。
6.组织学亚型
(1)嗜酸细胞腺瘤 单发,界限清楚,包膜完整,具有特征性的红褐色外观,常见中央区瘢痕形成。构成肿瘤的细胞有富含颗粒的嗜酸性胞浆,核大和明显的核仁,胶质常浓染并可形成类似沙砾体的结构,局部可见到乳头结构(图3-32至图3-34)。

图3-32 嗜酸性细胞腺瘤
图3-33 嗜酸性细胞腺瘤
图3-34 嗜酸性细胞腺瘤
(2)伴乳头状增生的滤泡性腺瘤:通常有包膜并部分囊性,瘤组织由宽的或纤细分支乳头和滤泡形成,衬以柱状细胞并含有一致的、圆形和深染的核。此型好发于儿童和青少年。
(3)胎儿型腺瘤:微滤泡/梁状结构伴水肿间质,特别是在肿瘤的中央部位(图3-35)。
(4)非典型腺瘤:滤泡性肿瘤具有以下特征为富于细胞、核异型或不寻常的组织学形态(例如梭形细胞巢),而充分取材后不见血管和包膜侵犯,仍表现为良性过程(图3-36、图3-37)。
7.预后 滤泡性腺瘤完全切除后,没有进一步的风险。

图3-35 胎儿型腺瘤

图3-36 非典型腺瘤

图3-37 非典型腺瘤